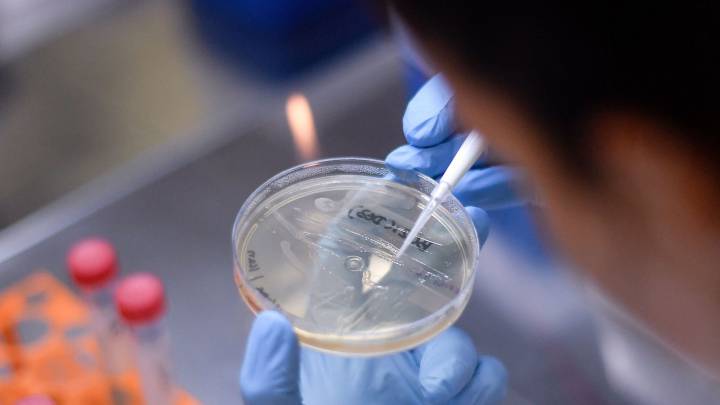

El Coronavirus Repite


Se Puede Contraer El Coronavirus Dos Veces San Diego Union Tribune En Espanol
www.sandiegouniontribune.com

La Gripe Espanola Al Covid 19 Del 2020 Como Se Repite La Historia Un Siglo Despues Yakima Y Tri Cities Noticias Locales Telemundo
www.telemundoyakimatricities.com

Alerta Al Consumidor Pruebas De Anticuerpos Para Covid 19 Todavia Se Estan Desarrollando Kaiser Health News
khn.org

Supuesta Profecia De Nostradamus Sobre Coronavirus Siembra Panico En Espanol Chicago Tribune
www.chicagotribune.com
Can You Get The Coronavirus Twice Or Will You Have Immunity To It Business Insider
www.businessinsider.com

El Epidemiologo De Harvard Que Predice Que Este Ano Entre El 40 Y El 70 De La Poblacion Mundial Se Infectara Con El Coronavirus
www.xataka.com

Congreso De Estados Unidos Aprueba 8 300 Millones De Dolares Contra El Coronavirus El Economista
www.eleconomista.com.mx
Usa Covid 19 Estas Fueron Las Noticias Del Covid 19 Y De Las Protestas En Estados Unidos Del 7 De Julio Marca Claro Usa
us.marca.com

Descubre Quienes Son Las Celebridades Latinas Mas Afectadas Por El Coronavirus Mientras Siguen En Cuarentena Los Angeles Times
www.latimes.com

Pruebas Del Covid 19 Tienen Un 10 15 Porcentaje De Producir Resultados Negativos Falsos Pero Un Patologo Aun Tiene Esperanza En Resultados Para Tratamiento Abc7 San Francisco
abc7news.com




























.webp)